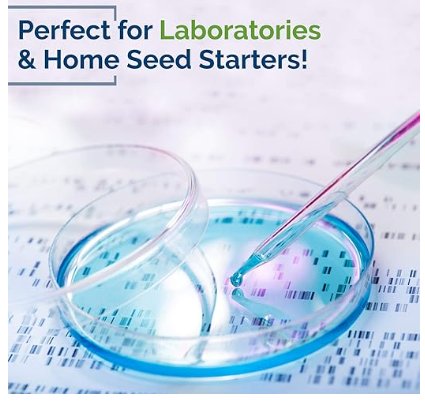

You must be logged in to bid.
Bidders are responsible for conducting their own product research.
*GENERIC CONDITION STATEMENT* This Item is in brand new condition exactly as if purchased from an online retailer and shipped to you or if purchased in person at a retail store. This item will either be factory sealed if it is originally sold with a seal, or it will be in brand new condition if sold with an open flap lid or package. This item will have its retail tags as if purchased from a retail store. (However, see photos of the packaging, as even though the item is brand new the packaging maybe distressed due to shipping, see our package condition for confirmation)